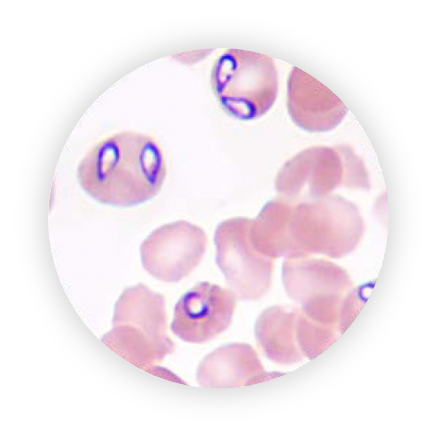

BRAVECTO CHEWABLE TABLET FOR DOGS AT A GLANCE
Long-lasting

Up to 12 weeks of protection available in
a single chew.
Fast-acting

Kills fleas and ticks
within a few hours of administration.1,2
Safety Demonstrated

BRAVECTO (fluralaner) is backed by many clinical studies and is indicated in puppies from 8 weeks of age onwards. 1-5
Convenient

Long lasting protection makes it easy for pet owners to protect pets year-round.6
ACHIEVE YEAR-ROUND COVERAGE WITH CONTINUOUS LONG-LASTING PROTECTION
When pet owners miss a dose, they create a gap in their pet’s protection.

49% of pet owners
purchasing monthly oral products average fewer than two doses per year.6
Compliance
Long-lasting protection provides fewer opportunities for gaps in coverage with fewer doses than monthly products.6

BRAVECTO Chewable tablet for dogs AND PARASITE PROTECTION IN DETAIL
Protection against fleas

Development from eggs to adult can be as fast as 14 days or as long as 140 days.7

BRAVECTO stops the life cycle in one dose and kills fleas before they can produce fertile eggs.5

Continuous use of BRAVECTO prevents flea re-infestation in pets & the household.5

Protection against ticks

BRAVECTO acts fast: starts acting
within 4 hours.2

BRAVECTO action lasts: ticks killed
within 12 hours and lasts up to 12 weeks.5

BRAVECTO offers flexibility in the mode of administration.
Tick Species5

Ixodes ricinus

Dermacentor
reticulatus

Rhipicephalus sanguineus
Reduce the risk of vector-borne diseases8-10
BRAVECTO Chewable tablets for dogs reduced the risk of infection with Babesia canis canis.8,9

BRAVECTO reduces the risk of transmission of flea tapeworms (Dipylidium caninum) from infected fleas to dogs for up to 12 weeks.10
THE LEADING LONG-LASTING SYSTEMIC FLEA AND TICK PROTECTION
BRAVECTO Chewable tablet for dogs outlasts monthly alternatives
PET OWNERS PREFER BRAVECTO
BRAVECTO is designed to give Pet Owners uninterrupted and worry-free time with their pets.
Four simple doses mean peace of mind for nearly the full year and fewer doses to remember.

Pet Owner satisfaction in the UK and US.12

of UK Pet Owners prefer the convenience of BRAVECTO vs. monthly products.12

Owners using BRAVECTO were more compliant with heartworm prevention.16

WHAT DO BRAVECTO tablets DO FOR DOGS?
Just one dose of BRAVECTO Chewable tablets for dogs protect your canine patients (and their homes) from the dangers posed by fleas and ticks continuously for up to 12 weeks.5
HOW DO I PROTECT MY CANINE PATIENTS
Direct dog owners to give one dose at or around mealtime for up to 12 weeks of lasting parasite protection.5

BRAVECTO IS HERE TO SUPPORT you
We have the tools to help you start the conversation with pet owners about why year-round protection is important.
Be the answer and start sharing BRAVECTO today!
PRESCRIBING BRAVECTO CHEWABLE TABLET FOR DOGS

BRAVECTO Chewable tablet for dogs is available for dogs from 2 kg and larger, and the flavoured chew is designed to make administration easy. Direct pet owners to give their dogs our tasty chew at, or around, mealtimes and let them chomp their way to long-lasting flea and tick protection. 5
FAQS
The following frequently asked questions (FAQs) can help answer additional questions you may have.
Fluralaner is a potent inhibitor of arthropod nervous system function by acting antagonistically on ligand-gated chloride channels (GABA-receptors and glutamate-receptors). These are insect and acarine specific GABA-gated chloride channels (GABACI) and glutamate-gated chloride channels (GluCI). Fluralaner at expected clinical concentrations showed no activity on the mammalian nervous system GABACI receptor. 17
Fluralaner, the active ingredient in BRAVECTO, is rapidly absorbed and distributes systemically into skin and other tissues. Fluralaner is not metabolised to a major extent and is mainly excreted unchanged in the faeces.5
Yes, fleas and ticks can be a year-round problem, even indoors (fleas and brought-in ticks). Administering BRAVECTO every 12 weeks ensures dogs will be protected from fleas and ticks throughout the year (The recommended retreatment interval may be 8 weeks for some ticks).
BRAVECTO has a high margin of safety. In safety studies3, BRAVECTO was tested in dogs and puppies at up to 5X the recommended dose at 8 weeks intervals for three consecutive treatments. Therefore, adverse effects beyond those reported on the prescribing information are not expected if dogs are inadvertently treated twice before the recommended retreatment interval has elapsed.
BRAVECTO first received regulatory approval in early 2014. It is backed by many clinical studies and over 80 published papers.
Yes, 8-weeks-old puppies were treated at doses of up to 280 mg fluralaner / kg body weight with BRAVECTO Chew. In target animal safety studies, there was no evidence of medicine-related alterations in food consumption, body weight, clinical parameters or physical examination variables, or clinical pathology findings.3
Yes, in laboratory studies, fluralaner was administered to dogs and cats concurrently with other antiparasitic drugs with no adverse effects observed.18-20
A growing puppy should be dosed with a soft chew appropriate to the body weight at the time of treatment. The field studies conducted in the EU and the USA included growing puppies and there was no evidence of lack of efficacy. BRAVECTO showed very good and continuous efficacy throughout the 12-week interval in these puppies.
BRAVECTO Chewable tablet for dogs starts to kill fleas after 2 hours.1 The EMA SPC5 onset of effect (slowest time over the whole treatment interval to reach 90% efficacy for ticks and 95% efficacy for fleas) is:
BRAVECTO Chew: 8 hours for fleas and 12 hours for ticks.
BRAVECTO starts to kill fleas within 2 hours of administration and 100% flea killing efficacy is reached within 8 hours.5
BRAVECTO kills fleas before they can lay eggs.21
The flavour is pork-liver based and contains processed (hydrolysed) proteins, this flavour is also used in other pet foods and veterinary medicines.
Do YOU WANT TO KNOW MORE?
Complete the form so we can contact you*
General Contact Information
“*” indicates required fields
REFERENCES
- Taenzler, J. et al. Onset of activity of fluralaner (BRAVECTO™) against Ctenocephalides felis on dogs. Parasites & Vectors. 2014; 7,567. https://parasitesandvectors.biomedcentral.com/articles/10.1186/s13071-014-0567-6
- Wengenmeyer C et al. The speed of kill of fluralaner (BRAVECTO™) against Ixodes ricinus ticks on dogs. Parasites & Vectors. 2014;7:525. https://parasitesandvectors.biomedcentral.com/articles/10.1186/s13071-014-0525-3
- Walther, F.M., Allan, M.J., Roepke, R.K. et al. Safety of fluralaner chewable tablets (BRAVECTO™), a novel systemic antiparasitic drug, in dogs after oral administration. Parasites & Vectors. 7, 87 (2014). https://doi.org/10.1186/1756-3305-7-87
- Walther, F.M., Paul, A.J., Allan, M.J. et al. Safety of fluralaner, a novel systemic antiparasitic drug, in MDR1(-/-) Collies after oral administration. Parasites & Vectors.7, 86 (2014). https://doi.org/10.1186/1756-3305-7-86
- BRAVECTO™ [Package Leaflet]. Boxmeer, NL: Intervet Productions; 2019. https://medicines.health.europa.eu/veterinary/en/search-medicines
- Lavan R et al. Duration of annual canine flea and tick protection provided by dog owners in Spain. Parasites & Vectors. 2018;11:458. https://parasitesandvectors.biomedcentral.com/track/pdf/10.1186/s13071-018-3043-x
- European Scientific Counsel Companion Animal Parasites. Control of ectoparasites in dogs and cats: ESCCAP Guideline 03 Seventh edition. January 2022. Accessed March 8, 2023. https://www.esccap.org/uploads/docs/eiw2uedg_0720_ESCCAP_GL3__English_v18_1p.pdf
- Chiummo, R., et al., Field efficacy of fluralaner (BRAVECTO® chewable tablets) for preventing Babesia canis infection transmitted by Dermacentor reticulatus ticks to dogs. Parasites & Vectors, 2023. 16(1): p. 252.
- Taenzler, J., et al., Prevention of transmission of Babesia canis by Dermacentor reticulatus ticks to dogs treated orally with fluralaner chewable tablets (Bravecto). Parasit Vectors, 2015. 8: p. 305.
- Gopinath D et al. Topical or oral fluralaner efficacy against flea (Ctenocephalides felis) transmission of Dipylidium caninum infection to dogs. Parasites & Vectors. 2018;11:557. https://parasitesandvectors.biomedcentral.com/articles/10.1186/s13071-018-3140-x
- Williams H et al. Fluralaner, a novel isoxazoline, prevents flea (Ctenocephalides felis) reproduction in vitro and in a simulated home environment. Parasites & Vectors. 2014;7:275. https://parasitesandvectors.biomedcentral.com/articles/10.1186/1756-3305-7-275
- Lavan et al. Flea and tick treatment satisfaction, preference, and adherence of dog owners in the United States, United Kingdom, and Australia who treated their dog with fluralaner. Open Veterinary Journal. 2020, Vol. 10(2): 135–143.
- Djuric, M., et al., Efficacy of oral fluralaner for the treatment of canine generalized demodicosis: a molecular-level confirmation. Parasites & Vectors, 2019. 12(1): p. 270.
- Chiummo, R., et al., Efficacy of orally and topically administered fluralaner (BRAVECTO®) for treatment of client-owned dogs with sarcoptic mange under field conditions. Parasites & Vectors, 2020. 13(1): p. 524.
- Taenzler, J., et al., Efficacy of fluralaner administered either orally or topically for the treatment of naturally acquired Sarcoptes scabiei var. canis infestation in dogs. Parasites & Vectors, 2016. 9(1): p. 392.
- Lavan et al. A comparative analysis of heartworm medication use patterns for dogs that also receive ectoparasiticides. Parasites & Vectors. 2018 11:493.
- Gassel, M., et al., The novel isoxazoline ectoparasiticide fluralaner: selective inhibition of arthropod gamma-aminobutyric acid- and L-glutamate-gated chloride channels and insecticidal/acaricidal activity. Insect Biochem Mol Biol, 2014. 45: p. 111-24.
- Walther FM, Allan MJ, Roepke RK. Plasma pharmacokinetic profile of fluralaner (BRAVECTO™) and ivermectin following concurrent administration to dogs. Parasites & Vectors. 2015;8(1). doi: https://doi.org/10.1186/s13071-015-1123-8
- Walther FM, Fisara P, Allan MJ, Roepke RK, Nuernberger MC. Safety of concurrent treatment of dogs with fluralaner (BRAVECTO™) and milbemycin oxime – praziquantel. Parasites & Vectors. 2014;7(1). doi: https://doi.org/10.1186/s13071-014-0481-y
- Walther, F.M., P. Fisara, and R.K.A. Roepke, Safety of topical administration of fluralaner plus moxidectin concurrently with praziquantel in cats. Parasite Vectors, 2018. 11(1): p. 597
- Dryden M et al. Efficacy of fluralaner flavored chews (BRAVECTO™) administered to dogs against the adult cat flea, Ctenocephalides felis felis and egg production. Parasites & Vectors. 2015;8:364. https://parasitesandvectors.biomedcentral.com/articles/10.1186/s13071-015-0965-4

